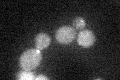
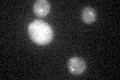

View description
Formin, nucleates the formation of linear actin filaments, involved in cell processes such as budding and mitotic spindle orientation which require the formation of polarized actin cables, functionally redundant with BNR1
Localization:
Intensity:
Fold change:
Significance:
-
C’ GFP library in SD
bud neckN/A -
N' NOP1pr-GFP in SD

punctate31.072 -
N' TEF2pr-mCherry in SD

punctate13.6861 -
N' NATIVEpr-GFP in SD

missing0 -
N' TEF2pr-VC and Cyto-VN in SD

#N/A0 -
C’ GFP library in SD+DTT
bud neckN/AN/ANo -
C’ GFP library in SD+H2O2

bud neckN/AN/ANo -
C’ GFP library in Starvation Media

bud neck180.79Yes -
C’ GFP library on the background of Pup2-DaMP

bud neck -
C’ GFP library on the background of CCT mutant

bud neck34.80271.53734Yes
